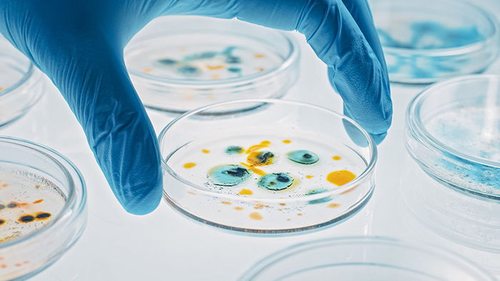

LifeStyle
13.08.2023 в 19:35
783
Имение расположено в лесистом английском селе Бидденден. Это - бывший городок металлургической промышленности.
|
Наука
13.08.2023 в 16:36
591
Молекулы для борьбы с микробами, которые когда-то присутствовали у неандертальцев и денисовцев, воссоздали в лабораторных условиях
|

Здоровье
13.08.2023 в 13:37
1109
В некоторых культурах даже считают, что от группы зависит темперамент, характер, индивидуальные особенности.
|

Общество
13.08.2023 в 11:25
870
Узнайте главные особенности, традиции и запреты сегодняшнего дня
|

LifeStyle
13.08.2023 в 09:07
1056
Узнайте, что ждет каждый из знаков зодиака с 14 августа по 20 августа 2023 года
|

Наука
13.08.2023 в 08:36
579
Появились новые доказательства того, что Марс не всегда был сухой и пустынной планетой. К тому же климат на планете менялся циклично.
|

Спорт
13.08.2023 в 07:14
728
Легендарный экс-голкипер сборной Италии решил повесить варежки на гвоздь в 45 лет.
|

Авто
13.08.2023 в 00:12
2571
Если вы все выполните правильно, то сможете успешно почистить геометрию турбины.
|

Статьи
13.08.2023 в 00:06
1363
Силиконовые ремешки обычно изготавливаются из мягкого и гипоаллергенного силикона, который приятен на ощупь.
|
|